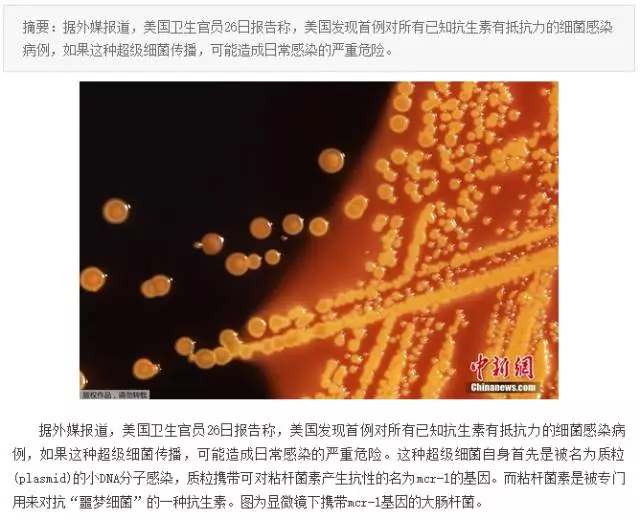
&ldquo;抗生素肉&rdquo;擺滿中國人餐桌，豬肉含量居然是牛肉的5倍!

幾年前,國際快餐界巨頭麥當(dāng)勞宣布將停用含HPCIA抗生素雞,而中國沒有出現(xiàn)在這項禁令的第一批名單中,麥當(dāng)勞的這一舉動引起國內(nèi)網(wǎng)友不滿,認為麥當(dāng)勞差別對待,不尊重中國市場。更有網(wǎng)友驚呼原來除了吃藥,吃肉也會增加耐藥性!真是活到老,學(xué)到老!!!
中國人一年用掉全世界一半的抗生素
近10年來全球抗生素的使用量增長了將近36%。

而我國在使用抗生素上更是瘋狂,我國每千人抗生素日使用量是英國的5.7倍,是美國的5.5倍之多。

如果目前的抗生素使用情況得不到相應(yīng)的改善,那么到2050年,全世界每年或?qū)⒂?000萬人因為抗生素耐藥性(AMR)問題而死亡。作為世界上濫用抗生素最嚴重的國家,中國每年或?qū)⒂?00萬人因此死亡,損失20萬億美元。這個數(shù)字遠超過了交通事故、糖尿病和霍亂致死人數(shù),甚至將超過癌癥。


不打針不吃藥就不用擔(dān)心抗生素了嗎?
從水源到食物抗生素出現(xiàn)在“不該出現(xiàn)的地方”
中科院廣州地化所應(yīng)光國課題組制作的《中國抗生素清單》中顯示出一條可怕的惡性循環(huán)鏈條正在危害人類健康。

人和養(yǎng)殖動物大量服用的抗生素絕大部分以原形排出體外,進入水環(huán)境中,再通過水產(chǎn)等食物進入人體,從而增加人體耐藥性并影響健康。
這一點在復(fù)旦大學(xué)公共衛(wèi)生學(xué)院有關(guān)“江浙滬兒童普遍暴露于多種抗生素”的研究中也有所體現(xiàn):在參與調(diào)查的1000個兒童中,至少有58%的兒童尿中檢一種抗生素,四分之一的兒童尿中檢出2種以上抗生素,有的尿液樣本中能檢出6種抗生素。金霉素、恩諾沙星、泰樂菌素,這三種一般只限于畜禽使用的抗生素,在這些兒童體內(nèi)均有檢出。
我們是在吃肉,還是在吃抗生素!
根據(jù)《美國國家科學(xué)院院刊》上發(fā)表的一項研究,由于全球?qū)θ忸愂称返男枨蠹眲∩仙谪i肉、牛肉和禽肉中的抗生素含量也在急劇飆升。

同樣重量的豬肉要比牛肉多使用4倍的抗生素,比雞肉多使用2倍。在我國,豬肉是主要的肉類食品。
為何中國不在麥當(dāng)勞首批名單?
畜類養(yǎng)殖中大量使用抗生素除了可以更快地催肥,也是為了避免疾病的流行。
上世紀(jì)90年代,丹麥曾禁止在豬飼料中使用四環(huán)素,導(dǎo)致養(yǎng)豬業(yè)產(chǎn)量減少和斷奶豬的死亡率提高。麥當(dāng)勞中國在聲明中也強調(diào):“在動物治病過程中使用抗生素是必須的。美國麥當(dāng)勞停用的某些人類使用的抗生素,并非完全停用抗生素”。
盲目抵制并不現(xiàn)實,在全球防控抗生素耐藥性蔓延的進程中,需要政策制定者、衛(wèi)生保健部門等多方的共同參與。
世界衛(wèi)生組織為個人以及農(nóng)業(yè)部門給出了建議:


在麥當(dāng)勞的時間表中:2018年1月,巴西、加拿大、日本、韓國、美國和歐洲市場停止使用HPCIA;到2019年年末,澳大利亞和俄羅斯停止使用,剩余的其他市場則要到2022年1月才完全停止使用。在這之前其供應(yīng)商會在獸醫(yī)的指導(dǎo)下用藥,藥品的種類、用法和用量嚴格遵守中國相關(guān)法律法規(guī)。”
抗生素是怎么開始在養(yǎng)殖業(yè)泛濫的
在養(yǎng)殖業(yè)中,抗生素最初是用來預(yù)防動物疾病的,在使用過程中,一些飼養(yǎng)者把抗生素的發(fā)酵殘渣加在飼料中喂豬,并發(fā)現(xiàn)用這種飼料比用普通飼料飼喂的仔豬長得更快。
Moore(1946)又發(fā)現(xiàn),在雞飼料中添加少量鏈霉素能促進雛雞的生長發(fā)育。以后許多人又陸續(xù)發(fā)現(xiàn)金霉素、地霉素等對犢牛、豬和禽等均有促進生長發(fā)育和育肥的作用。
在上個世紀(jì)60年代前后,有許多抗生素品種相繼問世并工業(yè)化生產(chǎn),研究者們幾乎對每個新問世的抗生素都作了以促進動物加速生長為目的的飼養(yǎng)試驗。研究結(jié)果肯定了多種抗生素具有刺激和加速動物生長的作用。這個消息很快在世界各地傳播開來,并引起各國的重視。

至此,抗生素作為畜禽飼料添加劑形成了一股極大的熱潮,全世界范圍內(nèi)都開始使用,而且使用量日益增加。據(jù)估計,我國每年抗生素原料生產(chǎn)量約為21萬噸,其中有9.7萬噸的抗生素用于畜牧養(yǎng)殖業(yè)。
隨著抗生素在飼料中長期大量使用,細菌耐藥性和食品安全問題也引起了全球的普遍關(guān)注。
畜牧養(yǎng)殖業(yè)濫用抗生素產(chǎn)生的危害
日糧中濫用抗生素使病原菌產(chǎn)生耐藥性
細菌可通過三種方式獲得耐藥性,一是在細菌繁殖的二分裂階段通過代與代之間進行傳遞。二是通過自發(fā)的基因突變產(chǎn)生。三是從附近其他的細菌細胞上獲得耐藥性基因。雖然耐藥性因子的傳遞頻率不高,但由于細菌數(shù)量大,繁殖快,仍易造成抗菌株的擴散蔓延。
抗生素濫用導(dǎo)致耐藥菌株增加,而抗生素飼料添加劑長期大量不合理使用是主要原因。
美國《新聞周刊》報導(dǎo),僅1992年美國就有13300名患者死于抗生素耐藥性的細菌感染。路透社1999年2月還報道了美國科學(xué)家在肉雞飼料中發(fā)現(xiàn)超級細菌,這種腸球菌對目前所有的抗生素具有耐藥性,超級細菌的產(chǎn)生給人類疾病的治療帶來極大的困難。

長期濫用抗生素,抗生素在機體內(nèi)殘留,影響人和動物的免疫和治療效果
當(dāng)機體攝入大量抗生素后,其跟隨血液循環(huán)遍布人體多個器官組織中,如淋巴結(jié)、腎、肺、骨骼、肝、脾、胸腺等各組織器官,造成動物機體的免疫能力逐漸降低,使慢性疾病增多而且頻發(fā)。

同時,抗生素還導(dǎo)致抗原質(zhì)量降低,對疫苗接種產(chǎn)生不良影響,為控制疫病的發(fā)生埋下了隱患。抗生素在治療人類疾病和畜禽疾病中的效果逐漸變差,為了起到治病效果,抗生素的用量也在不斷增大,形成了惡性循環(huán)。
長期超量使用抗生素,還易產(chǎn)生致病菌的交叉感染
使用抗生素,尤其是超量使用,會破壞腸道內(nèi)的微生態(tài)平衡,一方面使胃腸道內(nèi)對抗生素敏感性強的微生物減少,而敏感性差的菌群趁機大量繁殖,引起微生態(tài)失衡;

另一方面體內(nèi)的微生物被抗生素消滅后,為體外的微生物的侵入繁殖創(chuàng)造了條件,從而易產(chǎn)生致病的交叉感染,造成動物養(yǎng)殖越來越難。
中國人一年用掉全世界一半的抗生素
近10年來全球抗生素的使用量增長了將近36%。

而我國在使用抗生素上更是瘋狂,我國每千人抗生素日使用量是英國的5.7倍,是美國的5.5倍之多。

如果目前的抗生素使用情況得不到相應(yīng)的改善,那么到2050年,全世界每年或?qū)⒂?000萬人因為抗生素耐藥性(AMR)問題而死亡。作為世界上濫用抗生素最嚴重的國家,中國每年或?qū)⒂?00萬人因此死亡,損失20萬億美元。這個數(shù)字遠超過了交通事故、糖尿病和霍亂致死人數(shù),甚至將超過癌癥。


不打針不吃藥就不用擔(dān)心抗生素了嗎?
從水源到食物抗生素出現(xiàn)在“不該出現(xiàn)的地方”
中科院廣州地化所應(yīng)光國課題組制作的《中國抗生素清單》中顯示出一條可怕的惡性循環(huán)鏈條正在危害人類健康。

人和養(yǎng)殖動物大量服用的抗生素絕大部分以原形排出體外,進入水環(huán)境中,再通過水產(chǎn)等食物進入人體,從而增加人體耐藥性并影響健康。
這一點在復(fù)旦大學(xué)公共衛(wèi)生學(xué)院有關(guān)“江浙滬兒童普遍暴露于多種抗生素”的研究中也有所體現(xiàn):在參與調(diào)查的1000個兒童中,至少有58%的兒童尿中檢一種抗生素,四分之一的兒童尿中檢出2種以上抗生素,有的尿液樣本中能檢出6種抗生素。金霉素、恩諾沙星、泰樂菌素,這三種一般只限于畜禽使用的抗生素,在這些兒童體內(nèi)均有檢出。
我們是在吃肉,還是在吃抗生素!
根據(jù)《美國國家科學(xué)院院刊》上發(fā)表的一項研究,由于全球?qū)θ忸愂称返男枨蠹眲∩仙谪i肉、牛肉和禽肉中的抗生素含量也在急劇飆升。

同樣重量的豬肉要比牛肉多使用4倍的抗生素,比雞肉多使用2倍。在我國,豬肉是主要的肉類食品。
為何中國不在麥當(dāng)勞首批名單?
畜類養(yǎng)殖中大量使用抗生素除了可以更快地催肥,也是為了避免疾病的流行。
上世紀(jì)90年代,丹麥曾禁止在豬飼料中使用四環(huán)素,導(dǎo)致養(yǎng)豬業(yè)產(chǎn)量減少和斷奶豬的死亡率提高。麥當(dāng)勞中國在聲明中也強調(diào):“在動物治病過程中使用抗生素是必須的。美國麥當(dāng)勞停用的某些人類使用的抗生素,并非完全停用抗生素”。
盲目抵制并不現(xiàn)實,在全球防控抗生素耐藥性蔓延的進程中,需要政策制定者、衛(wèi)生保健部門等多方的共同參與。
世界衛(wèi)生組織為個人以及農(nóng)業(yè)部門給出了建議:


在麥當(dāng)勞的時間表中:2018年1月,巴西、加拿大、日本、韓國、美國和歐洲市場停止使用HPCIA;到2019年年末,澳大利亞和俄羅斯停止使用,剩余的其他市場則要到2022年1月才完全停止使用。在這之前其供應(yīng)商會在獸醫(yī)的指導(dǎo)下用藥,藥品的種類、用法和用量嚴格遵守中國相關(guān)法律法規(guī)。”
抗生素是怎么開始在養(yǎng)殖業(yè)泛濫的
在養(yǎng)殖業(yè)中,抗生素最初是用來預(yù)防動物疾病的,在使用過程中,一些飼養(yǎng)者把抗生素的發(fā)酵殘渣加在飼料中喂豬,并發(fā)現(xiàn)用這種飼料比用普通飼料飼喂的仔豬長得更快。
Moore(1946)又發(fā)現(xiàn),在雞飼料中添加少量鏈霉素能促進雛雞的生長發(fā)育。以后許多人又陸續(xù)發(fā)現(xiàn)金霉素、地霉素等對犢牛、豬和禽等均有促進生長發(fā)育和育肥的作用。
在上個世紀(jì)60年代前后,有許多抗生素品種相繼問世并工業(yè)化生產(chǎn),研究者們幾乎對每個新問世的抗生素都作了以促進動物加速生長為目的的飼養(yǎng)試驗。研究結(jié)果肯定了多種抗生素具有刺激和加速動物生長的作用。這個消息很快在世界各地傳播開來,并引起各國的重視。

至此,抗生素作為畜禽飼料添加劑形成了一股極大的熱潮,全世界范圍內(nèi)都開始使用,而且使用量日益增加。據(jù)估計,我國每年抗生素原料生產(chǎn)量約為21萬噸,其中有9.7萬噸的抗生素用于畜牧養(yǎng)殖業(yè)。
隨著抗生素在飼料中長期大量使用,細菌耐藥性和食品安全問題也引起了全球的普遍關(guān)注。
畜牧養(yǎng)殖業(yè)濫用抗生素產(chǎn)生的危害
日糧中濫用抗生素使病原菌產(chǎn)生耐藥性
細菌可通過三種方式獲得耐藥性,一是在細菌繁殖的二分裂階段通過代與代之間進行傳遞。二是通過自發(fā)的基因突變產(chǎn)生。三是從附近其他的細菌細胞上獲得耐藥性基因。雖然耐藥性因子的傳遞頻率不高,但由于細菌數(shù)量大,繁殖快,仍易造成抗菌株的擴散蔓延。
抗生素濫用導(dǎo)致耐藥菌株增加,而抗生素飼料添加劑長期大量不合理使用是主要原因。
美國《新聞周刊》報導(dǎo),僅1992年美國就有13300名患者死于抗生素耐藥性的細菌感染。路透社1999年2月還報道了美國科學(xué)家在肉雞飼料中發(fā)現(xiàn)超級細菌,這種腸球菌對目前所有的抗生素具有耐藥性,超級細菌的產(chǎn)生給人類疾病的治療帶來極大的困難。
長期濫用抗生素,抗生素在機體內(nèi)殘留,影響人和動物的免疫和治療效果
當(dāng)機體攝入大量抗生素后,其跟隨血液循環(huán)遍布人體多個器官組織中,如淋巴結(jié)、腎、肺、骨骼、肝、脾、胸腺等各組織器官,造成動物機體的免疫能力逐漸降低,使慢性疾病增多而且頻發(fā)。

同時,抗生素還導(dǎo)致抗原質(zhì)量降低,對疫苗接種產(chǎn)生不良影響,為控制疫病的發(fā)生埋下了隱患。抗生素在治療人類疾病和畜禽疾病中的效果逐漸變差,為了起到治病效果,抗生素的用量也在不斷增大,形成了惡性循環(huán)。
長期超量使用抗生素,還易產(chǎn)生致病菌的交叉感染
使用抗生素,尤其是超量使用,會破壞腸道內(nèi)的微生態(tài)平衡,一方面使胃腸道內(nèi)對抗生素敏感性強的微生物減少,而敏感性差的菌群趁機大量繁殖,引起微生態(tài)失衡;

另一方面體內(nèi)的微生物被抗生素消滅后,為體外的微生物的侵入繁殖創(chuàng)造了條件,從而易產(chǎn)生致病的交叉感染,造成動物養(yǎng)殖越來越難。
農(nóng)先鋒網(wǎng)聲明:凡資訊來源注明為其他媒體來源的信息,均為轉(zhuǎn)載自其他媒體,并不代表本網(wǎng)站贊同其觀點,也不代表本網(wǎng)站對其真實性負責(zé)。您若對該文章內(nèi)容有任何疑問或質(zhì)疑,請立即與網(wǎng)站(m.aiziwang.com)聯(lián)系,本網(wǎng)站將迅速給您回應(yīng)并做處理。
聯(lián)系郵箱:3267146135@qq.com
聯(lián)系郵箱:3267146135@qq.com







